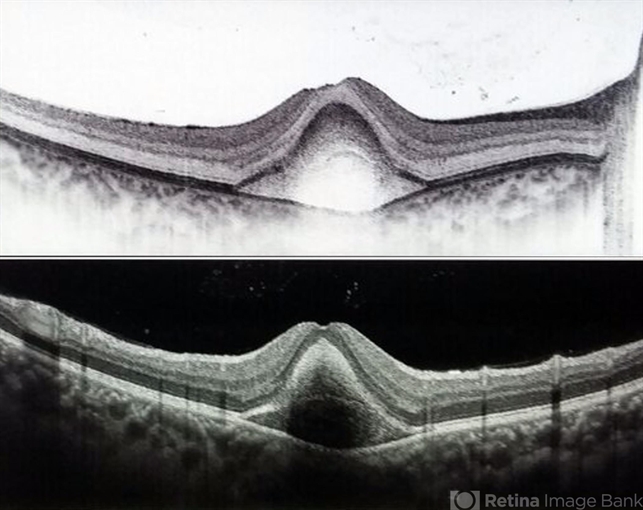
file

-
 By Hashim Ali Khan, OD, FAAO
By Hashim Ali Khan, OD, FAAO
SEHHAT Foundation Hospital - Uploaded on Dec 14, 2016.
- Last modified by Hashim Ali Khan, OD, FAAO on Dec 15, 2016.
- Rating
- Appears in
- Miscellaneous
- Condition/keywords
- pigment epithelial detachment (PED), subretinal hemorrhage
- Imaging device
- Scanning laser ophthalmoscope
- Description
- OCT of a 20-year-old female after trauma with tennis-ball, showing a hemorrhagic PED. RPE is elevated. The second Hyper-reflective band corresponding to Bruchs membrane (BM complex) is visible.

Initializing download.
Initializing download.










